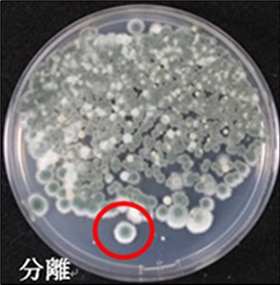

what
同定の定義は、「生物の分類上の所属や種名を決定すること」です。
同定を分かり易く説明すると、「カビだらけになっている物から、カビだらけにしている犯人を特定する」ということです。
同定することでカビの正体が分かり、正体が分かることで「どこからやってきたのか」、「人間に悪影響を与えるか」、「どう対処したら良いか」という情報を得ることが出来ます。
Flow
それでは、どのような操作で同定結果が得られるのでしょうか?
検査試料を受領してから同定結果が得られるまで、大きく分けて3つのステップがありますので、同定方法の各ステップを簡単にご紹介します。

まず、カビに汚染されていると思われる検査試料を、目視もしくは顕微鏡を用いて観察します。カビらしい形態が認められれば、このステップで、カビに汚染されていると大まかに判断することが出来ます。
目視や顕微鏡でカビらしい形態を確認できなかった場合は、次のステップまで進めて培養を行うことで、初めてカビがいるかいないかが解ります。
カビが生えていると思われる所から一部を採取して、カビ用の培地に移植・培養します。カビがいると培養後に色とりどりのカビが生えてきます。これらのカビを詳しく観察するために次のステップに進めます。

それぞれのカビを新たな培地の中央に移植し、単独で培養します。この培養方法を巨大培養と呼びます。巨大培養から、カビの生育速度・色・表面の状態等を肉眼的に観察すると同時に、顕微鏡でカビ胞子や菌糸の形態を観察します。得られた情報からカビを同定していきます。
カビは細菌と比較して発育速度が遅く、培地上で明確な姿が見られるようになるまで1~2週間かかります。そのため検査期間は、検査試料を受領してから同定結果が得られるまで、少なくとも3~4週間必要です。
necessity
カビは、現在10,000属100,000種が知られていると言われています。
全てのカビを確実に同定することは困難ですが、「敵を知り己を知れば百戦殆からず」という言葉にもあるように、カビによるトラブルを予防する為に、同定は必要な検査と言えます。
2014年11月情報館記事掲載
検査・調査のご相談、ご依頼がございましたらお気兼ねなくお問い合わせください。内容につきましては秘密保持を厳守いたします。
なお、対応は順次行っておりますが、お問い合わせが集中した場合はご回答に数⽇を頂くことがございますので予めご了承ください。
下記フォームにご記入ください。